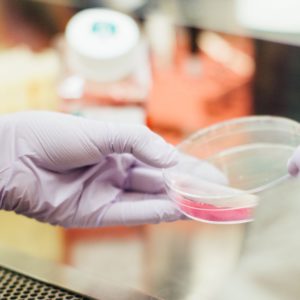

Veganisme draait in eerste instantie om het vermijden van het gebruik van dieren, maar het is gelukkig ook een milieuvriendelijke en duurzame levenswijze. De vee-industrie zorgt bijvoorbeeld voor 18% van de uitstoot van alle broeikasgassen en draagt significant bij aan water-, bodem- en luchtvervuiling.
In de onderstaande artikelen kun je meer lezen over de invloed van de vee-industrie op onze planeet en de milieuvoordelen van een veganistische levenswijze.
jun
2020
Waarom is veganist worden goed voor het milieu?
Waar veel mensen niet bij stil staan, is dat vlees eten en melk drinken enorm slecht is voor het milieu. Het is een van de grootste oorzaken voor het opwarmen van de aarde. Waarom? Elise legt het je uit.

Waarom is veganist worden goed voor het milieu?
Waar veel mensen niet bij stil staan, is dat vlees eten en melk drinken enorm slecht is voor het milieu. Het is een van de grootste oorzaken voor het opwarmen van de aarde. Waarom? Elise legt het je uit.

Het kopen van kleding: waar let je op?
Veganisme is meer dan alleen plantaardig eten. Maar waar moet je op letten bij het kopen van veganistische kleding? Nicky vertelt het je!

Waarom eigenlijk geen vis?
Waarom eten veganisten eigenlijk geen vis? En is vis eigenlijk gezond? Nicky vertelt je hier alles over in deze nieuwe blog!

Milieuvoordelen van plantaardig eten: minder voedselverspilling
Wist jij dat plantaardig eten niet alleen beter is voor de dieren, maar ook voor je medemens? Door de enorme verspilling van grondstoffen in de vee-industrie zouden we veel meer mensen kunnen voeden als iedereen plantaardig zou eten. Hoe dit precies zit legt Lisette je uit in deze blog.

Waarom eigenlijk geen honing?
In de serie ‘Waarom eigenlijk geen ..?’ legt Nicky je uit waarom veganisten bepaalde producten niet consumeren. In deze blog legt zij uit wat er mis is met honing en hoe je dit kunt vervangen.

Milieuvoordelen van plantaardig eten: Watergebruik
Plantaardig eten heeft ongelofelijk veel voordelen. Zowel voor je gezondheid, als voor de dieren, maar ook voor het milieu! Een reden waar wellicht wat minder mensen bij stilstaan, is watergebruik. Het is zeker niet onbelangrijk om hier aandacht aan te besteden! In dit blog ga ik jullie meer informatie geven over de besparing rondom drinkwater …

CO2 en een plantaardige levenswijze: hoe zit dat eigenlijk?
Hoe heeft veganist worden eigenlijk invloed op je CO2 uitstoot? In deze blog legt Annemiek het uit!

Hoe dierlijke producten nuttigen leidt tot ontbossing
Ontbossing, wat weet je daar eigenlijk over? Grote kettingzagen, krakende bomen en dieren die op de vlucht slaan. En waarom eigenlijk? Voor onze houten tafels? Voor sojaproducten? Voor …. uh… hoe zit dit eigenlijk?

Misconceptie vegans eten ook biologisch!
Veganisme en biologisch eten wordt vaak aan elkaar gekoppeld. Maar waarom? Want wist je dat het helemaal niet hetzelfde is? De overlap is een veelvoorkomende misconceptie. Maya legt uit hoe het echt zit. Klik snel verder!

Wat betekent ‘biologisch’ eigenlijk?
Moet je eigenlijk ook biologisch eten als je vegan bent? Een vraag die vaak gesteld wordt aan het VeganChallenge-team. Maar wat is ‘biologisch’ eigenlijk? En wat heeft het voor effect op mens, dier en milieu? Elise legt het allemaal haarfijn aan je uit.

Wat is er mis met palmolie?
Palmolie, altijd een vaag onderwerp onder zowel vegans als alleseters. Want wat gebeurt er precies in de palmolie-industrie en hoe kunnen wij dit als consumenten beter maken? Elise vertelt hier het verhaal over palmolie.

Leer een onbelangrijk bijproduct? Echt niet!
Hoe erg is het kopen van lederen producten? Is het ‘gewoon’ een bijproduct of worden er dieren speciaal voor gefokt en geslacht? En wat voor effect heeft de leerindustrie op het milieu en de arbeiders? Elise legt het je hier haarfijn uit.
Het verhaal achter kweekvlees. Is het vegan?
Kweekvlees. Dat klinkt als dé ideale oplossing. Maar wat weten wij er eigenlijk van? Hoe ver zijn de ontwikkelingen eigenlijk op dit gebied? En, is het eigenlijk wel vegan?

Soja deel 2: Soja en het milieu
Als je eenmaal begint te lezen over wat de impact is van soja op het milieu, dan begint het je vast en zeker te duizelen. In dit blog legt Elise uit waar soja wordt verbouwd, waarom en hoe jij op een goede manier lekker soja kunt eten.

Hoe zit het met biologisch vlees?
Uitsluitend biologisch vlees eten lijkt voor veel mensen de oplossing voor een ethisch dilemma. In deze video vertelt Maya waarom biologisch niet perse beter is.

